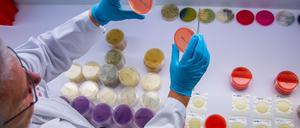
Im Labor des Landesamts für Landwirtschaft, Lebensmittelsicherheit und Fischerei untersucht ein Mitarbeiter Trägerplatten mit dem Bakterium bacillus cereus. Anhand der Proben können Mitarbeiter die Art und Anzahl von Keimen bei getesteten Lebensmitteln bestimmen. Derzeit werden verstärkt Proben auf Ehec untersucht.
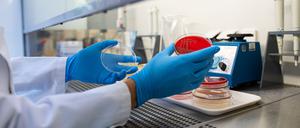
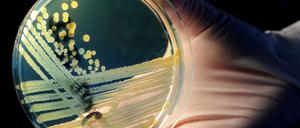

Die umstrittene Co-Chefin der Nachwuchsorganisation Grüne Jugend, Jette Nietzard, ist Geschichte. Doch auch die beiden neuen Vorsitzenden wollen unbequem sein.

Die umstrittene Co-Chefin der Nachwuchsorganisation Grüne Jugend, Jette Nietzard, ist Geschichte. Doch auch die beiden neuen Vorsitzenden wollen unbequem sein.

Am Dienstag jährt sich der Überfall der Hamas auf Israel zum zweiten Mal: Die Polizei rechnet mit Spontanversammlungen und wird mit 1000 Beamten mehr in Berlin präsent sein.

Zum Tag der Deutschen Einheit bietet Berlin wieder allerhand. Berliner können etwa kostenfrei das Deutsche Historische Museum besuchen oder die Gaukler auf der Zitadelle bewundern.

Am westlichen Stadtrand Berlins ist ein Wallaby ausgebüxt. Zwei Experten beantworten die interessantesten Fragen über die Tiere, die sich schon mehrfach in deutschen Wäldern vermehrt haben.

Er schlug auf Andersdenkende ein und griff Journalisten an: Der 18-jährige Neonazi W., auch „die Sirene“ genannt, ist am Dienstag festgenommen worden. Zudem gab es Durchsuchungen bei Gleichgesinnten.

Während bundesweit etwas mehr Organspenden verzeichnet werden, sinken die Zahlen im Nordosten Deutschlands deutlich. Dabei warten zahlreiche Menschen auf ein Spenderorgan.

Wie viel Macht hätte ein Ministerpräsident von der AfD, was könnte er politisch ganz konkret angehen? Der Blick auf fünf kritische Bereiche zeigt: eine ganze Menge.

Ein Jahr vor der Landtagswahl in MV bekommt Regierungschefin Schwesig eine Umfrage präsentiert, die ihr nicht gefällt. Auch in anderen Ost-Ländern ist die AfD stark. Kanzler Merz bekommt das zu hören.

Die SPD von Ministerpräsidentin Manuela Schwesig kommt in einer aktuellen Umfrage nur noch auf die Hälfte der Stimmen der Landtagswahl von 2021. Nicht einmal eine Dreierkoalition abseits der AfD wäre mehr möglich.

Anfang 2027 wird die Nachfolge Frank-Walter Steinmeiers gewählt. Zieht erstmals ein weibliches Staatsoberhaupt ins Schloss Bellevue? Ein Name wird immer wieder genannt. Wichtige Fragen und Antworten.

Brandenburgs Ministerpräsident Dietmar Woidke (SPD) nutze eine Feierstunde zum 35-jährigen Bestehen des Landtags für eine versteckte Regierungserklärung.

Das chinesische Unternehmen Dreame prüft nach eigenen Angaben ein E-Autowerk in Brandenburg, nicht weit von Tesla entfernt. Die Landesregierung hält sich mit Details aber bedeckt.

Bei einer gemeinsamen Kabinettssitzung geht es um eine engere Zusammenarbeit beider Länder. Einig ist man sich vor allem im Punkt Verkehr.

Sexistische Sprüche auf offener Straße könnten bald strafbar sein. Sieben Bundesländer sprechen sich laut einem „Spiegel“-Bericht klar für ein gesetzliches Verbot aus.

Das Digital-Projekt „TENEAM“ soll insbesondere in dünn besiedelten Gebieten bei der Versorgung helfen. Das Nachbarland Mecklenburg-Vorpommern ist mit dabei.

In Umfragen stehen die Grünen im Nordosten schlecht da, nun schwächt ein Streit die Partei weiter. Kurz vor dem Landesparteitag droht Chaos.

Verkehrsminister Detlef Tabbert erwägt eine Überarbeitung der Ausschreibung der Bahnlinien RB73 und 74. Gespräche mit Mecklenburg-Vorpommern stehen bevor, um über die Zukunft der Bahnlinien zu diskutieren.

Geredet wird über den Einsatz von KI an Schulen viel. Doch eine Umfrage des Tagesspiegels zeigt: Längst nicht in allen Landesteilen ist sie schon in den Klassen- und Lehrerzimmern angekommen.

Die Staatsanwaltschaft ermittelt gegen Innenstaatssekretär Schmülling und Polizeichef Walus wegen Untreue bei der Beschaffung von Corona-Schutzausrüstung.
Der Ehec-Ausbruch in Mecklenburg-Vorpommern kommt nicht zum Stillstand. Die Behörden melden viele neue Ansteckungen. Die Suche nach der Infektionsquelle bleibt weiter ohne Erfolg.

Bereits Jahre vor dem Anschlag in Magdeburg fiel Taleb A. psychisch auf. Ein damaliger Ermittler sagte nun im Parlamentarischen Untersuchungsausschuss aus.

Die Menschen in Nordrhein-Westfalen haben abgestimmt. Die CDU kann sich als stärkste Kraft behaupten. Die SPD und vor allem die Grünen müssen Einbußen hinnehmen.

Hitze, Dürren und Überschwemmungen: Der Sommer 2025 kostet die EU mehr als alle Naturkatastrophen 2024 zusammen.

Nach einem EHEC-Ausbruch in Mecklenburg-Vorpommern sind auch vier Kinder im Landkreis Oberhavel betroffen. Was das Robert Koch-Institut zur Ursache sagt.

Der Ehec-Ausbruch in Mecklenburg-Vorpommern trifft auch Kinder aus anderen Bundesländern, etwa weil sie ihre Ferien im Nordosten verbrachten. Wie die Lage in Berlin und Brandenburg aussieht.

In Mecklenburg-Vorpommern stecken sich immer mehr Menschen mit lebensgefährlichen Ehec-Keimen an. Zahlreiche Fachleute suchen unter Hochdruck nach dem Ursprung – doch das ist komplizierter als gedacht.

Am Donnerstag reiste Robert Crumbach (BSW) zum ersten Mal offiziell nach Stettin – und wurde freundlich empfangen. Es gab einige Vereinbarungen, unter anderem auch im Umgang mit der EU.

In Mecklenburg-Vorpommern infizieren sich immer mehr Menschen mit Ehec. Vergangene Woche entwarnten die Behörden in Berlin noch – nun gibt es mehrere neue Fälle in der Hauptstadtregion.

Die Zahl der gemeldeten Fälle in Mecklenburg-Vorpommern ist auf 31 gestiegen. 2011 endete ein ähnlicher Ausbruch mit mehr als 50 Toten.

In Mecklenburg-Vorpommern ist die Zahl der Infektionen mit dem gefährlichen Darmkeim Ehec auf 31 gestiegen. Das Landesamt für Gesundheit und Soziales meldet weitere Fälle vor allem bei jüngeren Kindern.

Im kommenden Jahr werden fünf Landtage neu gewählt. In Baden-Württemberg müssen die Grünen um ihre Macht bangen. In Sachsen-Anhalt könnte es zu einem Regierungschef der AfD kommen.

Gemessen an der Bevölkerungszahl sind Delikte mit rechter politischer Motivation im Osten Deutschlands laut Angaben der Regierung häufiger als im Westen. In Brandenburg wurden im ersten Halbjahr mehr als 1660 Taten erfasst.

Die Zahl der Ehec-Fälle in Mecklenburg-Vorpommern steigt. Noch ist unklar, wie es zu den Infektionen kam. Die Suche nach der Quelle der Infektionen läuft.
Die Zahl der Ehec-Fälle in Mecklenburg-Vorpommern steigt. Noch ist unklar, wie es zu den Infektionen kam. Die Suche nach der Ursache läuft.

National Guardian heißt das Manöver, mit dem die Nato ihre Verteidigungsfähigkeit prüft. Beelitz bei Berlin wird zur Drehscheibe für Konvois auf dem Weg Richtung Osten.

In Brandenburg versorgt ein Hausarzt im Schnitt deutlich mehr Patienten als in Bayern. Ein großer Teil wird zudem bald aus dem Berufsleben aussteigen.

Das von der Rückrufaktion betroffene Produkt war in elf Bundesländern erhältlich. Ob eine Verbindung zum Ausbruch des Erregers in Mecklenburg-Vorpommern besteht, wird geprüft. Dort gibt es bereits 17 Fälle.
In Mecklenburg-Vorpommern häufen sich Ehec-Fälle. Die Bakterien können schwere Erkrankungen verursachen. Auch in Berlin gibt es mehr Fälle als vor Jahren – doch dafür gibt es einen plausiblen Grund.

Vier Kinder befinden sich aufgrund der Erkrankung auf Intensivstationen. Übertragen wird diese gemeinhin durch verunreinigte Lebensmittel. Grund zur Panik sehen die Gesundheitsbehörden indes nicht.

Ein 45-Jähriger soll in Mecklenburg-Vorpommern Kinder beim Spielen mit einer Softair-Pistole beschossen haben. Sechs Jungen erlitten dabei leichte Verletzungen.
öffnet in neuem Tab oder Fenster